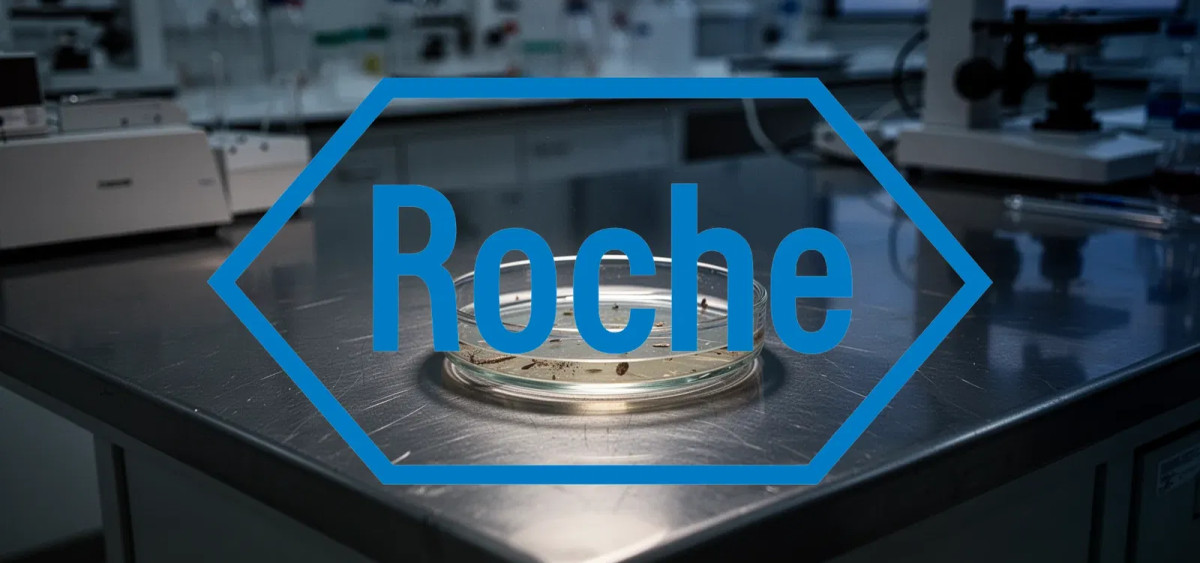
Beitragsbild zu Roche Aktie: Studien-Flop belastet

Roche Aktie: Studien-Flop belastet
Roche-Anleger mussten zuletzt einen herben Dämpfer hinnehmen. Die Hoffnung auf einen schnellen Durchbruch in der Brustkrebstherapie hat sich vorerst zerschlagen, nachdem ein zentraler Hoffnungsträger die gesteckten Ziele verfehlte.
Rückschlag in der Onkologie
Der Wirkstoff Giredestrant konnte in der sogenannten Persevera-Studie die primären Ziele nicht erreichen. Konkret gelang es nicht, eine statistisch signifikante Verlängerung des progressionsfreien Überlebens bei den Patienten nachzuweisen. Da das Marktsegment für Brustkrebstherapien als strategisch wichtig gilt, wiegt dieser Rückschlag für die klinische Pipeline schwer.
Die Nachricht traf das Unternehmen in einem bereits volatilen Marktumfeld. Der Verkaufsdruck drückte den Kurs am Donnerstag auf einen Schlusskurs von 353,00 Euro. Damit notiert der Titel nun rund 13,8 % unter seinem 52-Wochen-Hoch von 409,45 Euro, das erst im Februar erreicht worden war.
Uneinigkeit unter Experten
Die Reaktion der Analysten fiel geteilt aus. JPMorgan senkte das Kursziel von 350 auf 325 Schweizer Franken und verwies dabei auch auf Risiken bei anderen Projekten wie dem MS-Wirkstoff Fenebrutinib. Jefferies bleibt mit einem Ziel von 230 Schweizer Franken sogar noch deutlich pessimistischer und stuft den Wert weiterhin als „Underperform“ ein.
Ein Kontrastprogramm bietet Barclays: Analyst James Gordon sieht trotz der enttäuschenden Daten ein langfristiges Umsatzpotenzial von 1,3 Milliarden US-Dollar für Giredestrant und hält an seinem Kursziel von 410 Schweizer Franken fest.
Roche muss nun beweisen, dass andere Projekte in der Onkologie – etwa im Bereich der T-Zell-Engager oder neue Ansätze bei p53-Mutationen – den Fehlschlag kompensieren können. Im weiteren Jahresverlauf werden zusätzliche Daten aus dem Forschungsportfolio erwartet, die für die langfristige Wachstumsstory und die Kompensation der entstandenen Lücke entscheidend sind.
Roche-Aktie: Kaufen oder verkaufen?! Neue Roche-Analyse vom 13. März liefert die Antwort:
Die neusten Roche-Zahlen sprechen eine klare Sprache: Dringender Handlungsbedarf für Roche-Aktionäre. Lohnt sich ein Einstieg oder sollten Sie lieber verkaufen? In der aktuellen Gratis-Analyse vom 13. März erfahren Sie was jetzt zu tun ist.
Roche: Kaufen oder verkaufen? Hier weiterlesen...













